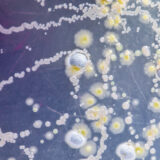

Consumers have millions of clothing retailers at their fingertips — and apparel companies need to meet customer expectations to beat out the competition.
Now more than ever, consumers seek a streamlined user experience from companies that align with their values. This is a high bar for many retailers who struggle to make a profit at cutthroat margins, but we have the formula to save on return costs and build brand loyalty among your customers.
1. Free Shipping & Returns
Since the dawn of online shopping, retailers have guaranteed free shipping and returns as a way to build trust from their consumer base. Promising high-quality products that fit as described, the free return was intended as a show of good faith. But new consumer behaviors have turned the free return into a costly burden for retailers.
Since the pandemic, online shopping has skyrocketed and nearly replaced the traditional brick-and-mortar shopping experience for apparel. And since they aren’t able to try on their online orders, shoppers might make larger purchases, with the intention to try on and send back items that they aren’t sure about. This practice especially hurts online retailers who are shelling out millions in postage costs and not seeing the return on their investment.
The best way to reduce return and restock costs is to implement a stricter return policy. Shorter return windows and requirements for tags can be a good place to start. With less time to send back unwanted items, shoppers are less tempted to make a large purchase with the intention of only keeping one item.
You can also keep free shipping without covering the return postage. Online shopping isn’t new anymore (it’s pretty much the norm), so you don’t need to make these big promises to show customers that you’re a legitimate business. Instead, focus on the quality of your items and their fit so that fewer customers will encounter your return policy to begin with. And if they do need to send something back, it won’t cut into your bottom line.
2. Aligned Values
Researchers have found that younger Millennial and Gen Z shoppers prefer to spend their hard-earned cash with brands that share their values. For most shoppers in this demographic, a dedication to sustainability is a must.
These consumers were raised on “Reduce, Reuse, Recycle” and have a greater consciousness for the environment. And what many of them don’t realize is that their shopping habits contribute to landfills around the world.
Due to market pressure to keep prices low and offer free shipping, retailers have opted to send apparel returns to the landfill rather than sanitizing and restocking. This has been apparel’s dirty little secret for over 10 years, and savvy apparel retailers need a better solution if they want to keep Gen Z’s business.
3. Quality Items
With tight budgets in mind, many shoppers these days are living by the motto “I’m too poor to buy cheap stuff.” They’re looking for high-quality staple items that will be part of their wardrobe for years to come.
If your model is quick turn and burn, you might have a problem with building customer loyalty — and you’ll probably see a mountain of returns. When money is tight, people are going to return purchases that don’t meet their standards, costing you much more in the long run.
We understand that tight margins are what keep prices low, but we recommend paying attention to consumer trends that favor longer-lasting apparel, even if it comes at a higher price point.
4. Safe to Wear
Do you remember when consumers first realized their “new” clothes weren’t always all that new? 10 years ago, a bombshell article informed customers that retailers weren’t always sanitizing returned clothes before they were back on the shelf.
One brand saw the public outcry and decided to take proactive measures to make sure their good name wouldn’t get caught up in the controversy. With over $10 billion in yearly revenue, protecting their reputation was worth it. They worked with the Global Ozone team to build a custom, state-of-the-art return stock sanitizing system, preventing their returned products from ending up in a landfill or on a shelf without proper disinfection.
Now, they’ve got disinfection down to a science. Processing millions of garments every year, this apparel retailer can promise customers sustainable fashion that’s safe to wear at a reasonable price point, all thanks to ozone disinfection.
Do you want to build a better reputation for your apparel company? Reach out to Global Ozone to learn about custom sanitizing solutions at any scale.